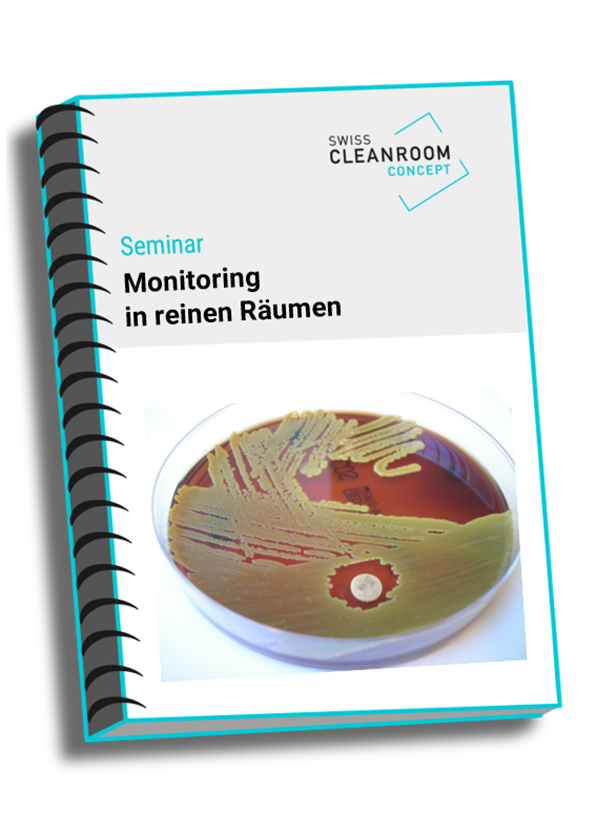
Monitoring in reinen Räumen

GMP- und Reinraum-Seminare
Grösster Anbieter für GMP und Reinraum Seminare in der Schweiz.
Über 50 Referenten aus der Praxis. Immer am Puls der Zeit.
Berufliche Funktionen
Reinraum Praxisseminar
Seminar-Themen
✓ Schutzkonzepte für reine Räume
✓ Verhalten in reinen Räumen
✓ Workshop:
Schutzkonzepte
Verhaltensweisen in reinen Räumen
✓ Anforderungen an die Reinraumbekleidung
✓ Workshop:
Wie kann ich Fehler beim Anziehprozedere vermeiden
✓ Reinigungs- und Desinfektionstechniken für Reinräume
Qualifizierung von Anlagen und Utilities
Seminar-Themen
✓ Anforderungen an die Qualifizierung
✓ Änderungen im Concept Paper zur Revision von Annex 15 (2026)
✓ Vorgaben des Annex 15
✓ Der risikobasierte Ansatz
✓ Änderungen in der ICH Q9
✓ Qualifizierung einer Reinstwasseranlage
✓ Qualifizierung reiner Räume
✓ Qualifizierung von Sterilisationsapparaten
✓ Qualifizierungsanforderungen an pharmazeutische Gase
Kontaminationskontrollstrategie sinnvoll umsetzen
Seminar-Themen
✓ Annex 1 - Kontaminationskontrollstrategie (CCS)
✓ Beispiel einer Kontaminationskontrollstrategie
✓ Anforderungen an Sterilfilter-Integrity-Testing
✓ Workshop: Annex 1 CCS GAP Analyse
✓ Wo braucht es die QA-Oversight?
✓ Media fill – Aseptic process simulation
✓ Anforderungen aseptische Herstellung
✓ Anforderungen End-Sterilisation
✓ Anforderungen an den PUPSIT
Anforderungen an Single use Systeme
Seminar-Themen
✓ Annex 1 - Anforderungen an Single use Systeme
✓ Sterilfiltration in der aseptischen Herstellung
✓ Anforderungen an Sterilfilter-Integrity-Testing (PUPSIT)
✓ SU-Flüssigkeitspfad und dessen regulatorischen Aspekte
✓ SU-Technologie mit Schwerpunkt auf Pumpen
✓ Single Use- Technologie in der Biopharma
✓ Besichtigung der Firma avintos AG in Rheinfelden
Anforderungen an die Sterilisation
Seminar-Themen
✓ Übersicht über die Sterilisationsverfahren
✓ Behördliche Anforderungen z.B. Annex 1 an die Sterilisation
✓ Sterilfiltration in der aseptischen Herstellung
✓ Anforderungen an Sterilfilter-Integrity-Testing (PUPSIT)
✓ Praktische Aspekte der Dampfsterilisation von Sterilfiltern
✓ Heissluftsterilisation und Entpyrogenisierung
✓ Dampfsterilisation
✓ Praktische Aspekte der Dampfsterilisation von Sterilfiltern
Sicherer Umgang mit Zytostatika
Seminar-Themen
✓ Was sind Zytostatika?
✓ Parenteralia Herstellung in aseptischen Reinraumzonen
✓ Gefährdungspotential bei der Herstellung
✓ Workshop „technische Werkbank Überprüfung“
✓ Sicherheitswerkbank theoretisch
✓ Workshop „Desinfektion und Zyto Herstellung live“
✓ PSA - Worauf muss geachtet werden?
✓ Workshop „Zyto Havarie was tun? “
✓ Entsorgung von Zytostatika
1. Swiss Cleanroom Symposium
Aufgrund der grossen Nachfrage an den Swiss Cleanroom Community Events, die Themen rund um den Reinraum in einem grösseren Fachkreis zu diskutieren, findet neu das 1. Swiss Cleanroom Symposium statt.
Das Format des Symposiums lehnt sich an das bewährte Eventprogramm an, wobei beim Symposium die Referatslänge verlängert wurden, womit den Referenten und Teilnehmern ein fachlicher Diskurs ermöglicht wird.
Zudem wird ein Gastreferent, jeweils dem Ganzen eine spezielle Note verleihen. Die 15 Aussteller werden den Teilnehmern in den Pausen und im anschliessenden Apèro riche die Plattform geben, um sich über die verschiedenen Fachthemen auszutauschen.
Learnings durch den neuen Annex 1
Seminar-Themen
✓ Der neue Annex 1 – Sterile und aseptische Herstellung
✓ Annex 1 – Aufbau und wichtige Bestandteile
✓ Der Annex 1 und dessen Einfluss auf Fill-Finish Facilities
✓ Auswirkung des Annex 1 auf die Reinraumqualifizierung
✓ Erfahrungen bei der Umsetzung der Annex 1 Anforderungen
✓ Annex 1 - Kontaminationskontrollstrategie (CCS)
✓ Beispiel einer Kontaminationskontrollstrategie
✓ Swiss Medic interpretation of EU GMP Annex 1
✓ Konsequenzen auf die Reinraumbekleidung bzw. das Gowning
Fortbildung zum Reinraum-Manager
Seminar-Themen
✓ Annex 1 - Kontaminationskontrollstrategie (CCS)
✓ Beispiel einer Kontaminationskontrollstrategie
✓ Effektive CAPA (Corrective and Preventive Action)
✓ Anforderungen an die Reinraumbekleidung inkl. Workshop: Gowning
✓ Betriebs- und Personalhygiene
✓ Aufbau eines praxisorientierten Schulungskonzeptes
✓ Ablauf einer typischen Wartung / Revision im Reinraum
✓ Schutzkonzepte für reine Räume
✓ Reinigungs- und Desinfektionstechniken für Reinräume
✓ Outsourcing der Reinraumreinigung
✓ Workshop: Aufbau von reinen Räumen
✓ Dokumentation und Datenintegrität ALCOA++
✓ Leitfaden zu Audits und Inspektionen bei reinen Räumen
GMP-Grundlagen für Neueinsteiger
Seminar-Themen
✓ Einführung in GMP
✓ Qualitätsmanagementsysteme
✓ Personal, Schulung, Hygiene und Reinraumverhalten
✓ Betriebs- und Personalhygiene
✓ Räumlichkeiten, Ausrüstung und Materialien
✓ Dokumentation und Aufzeichnungen
✓ Abweichungen, CAPA und Audits
GMP-News 2026
Seminar-Themen
✓ Aktuelle Anforderungen an die Datenintegrität
✓ Was wird von ALCOA++ gefordert?
✓ Effektive CAPA, Change Control, Deviation
✓ Aufgabe der QA-Oversight
✓ Entwurf des Chapter 4 Dokumentation
✓ Entwurf Annex 11 CSV (Computer-System-Validierung)
✓ Entwurf Annex 22 Künstliche Intelligenz
Anforderungen an pharmazeutische Gase
Seminar-Themen
✓ Qualitätsanforderungen an pharmazeutische Gase
✓ Betrieb, Wartung und Monitoring von Gasverteilsystemen
✓ Qualifizierung von Gasverteilsystemen
✓ Anforderungen an sterile Gase
✓ Einsatz von Risikoanalysen
✓ Qualitätsmessungen von pharmazeutischen Gasen
✓ Keimmessung in der Druckluft und im Stickstoff
✓ Praktischer Durchführung von Messungen Druckluft
✓ Druckluftverbrauchsmessung
✓ Anforderungen an die Kalibrierung
✓ Press-Rohrleitungen für pharmazeutische Gase
Reinigungs- und Desinfektionsstrategie
Seminar-Themen
✓ Welche Produktreinheit wird gefordert
✓ Welche Schutzkonzepte werden hierzu benötigt?
✓ Aufbau einer Kontaminationskontrollstrategie (CCS)
✓ Wie wird das Produkt kontaminiert?
✓ Reinigung + Desinfektionsstrategie
✓ Mikrobiologisches Monitoring
✓ Mitarbeiter Training intern
✓ Schulung externer Dienstleister
✓ Outsourcing der Reinigung
✓ Inspektion der Reinraumreinigung
Qualifizierunganforderungen im GMP-Umfeld
Seminar-Themen
✓ Masterqualifizierungsplan – URS - DQ
✓ Änderungen im Concept Paper zur Revision von Annex 15 (2026)
✓ Good documentation practice (GDocP)
✓ Data integrity
✓ Einsatz von Risikoanalysen
✓ Lieferantenbewertungen
✓ Qualifizierungsphasen IQ, OQ und PQ und CSV
✓ Masterqualifizierungsreport
✓ Periodic review
✓ Wartung von pharmazeutischen Anlagen
✓ Ablauf einer typischen Wartung
✓ Anforderungen an die Kalibrierung
Audits und Inspektionen erfolgreich bestehen
Seminar-Themen
✓ Begriffe und Definition von Inspektionen und Audits
✓ Leitfaden zu Inspektionen und Audits
✓ Psychologische Aspekte bei Inspektionen und Audits
✓ Umgang mit Konflikten in Inspektionen und Audits
✓ Workshop anhand praktischer Beispiele / Feedback
✓ Regulatorische Aspekte
✓ Das FDA Quality Metrics Program
✓ Nachbearbeitung von Inspektionen und Audits
GMP-Basiswissen
Seminar-Themen
✓ Einführung in die GMP-Entwicklung
✓ Struktur der Behörden, Aufbau
✓ GMP-Abkürzungen
✓ Anforderungen an das Personal
✓ Umgang mit Abweichungen
✓ Change Control / sterile Produkte
✓ QM-System / QM-Handbuch
✓ Anforderungen die Qualifizierung
✓ Anforderungen die Validierung
Monitoring in reinen Räumen
Seminar-Themen
✓ Mikrobiologische Reinraumqualifizierung und Monitoring
✓ Mikrobiologie und Kontaminationen
✓ Anforderungen der EN 17141:2020 Biokontaminationskontrolle
✓ Annex 1 - Kontaminationskontrollstrategie (CCS)
✓ Messverfahren
In der Luft, auf Oberflächen und in der Umgebung
✓ Aufbau eines sinnvollen Messpunktes
✓ Anforderungen an ein Monitoring-System
✓ Blaulicht Dekontamination
GMP-Compliance im Fokus
Seminar-Themen
✓ Effektive CAPA (Corrective and Preventive Action)
✓ Deviation / Investigation
✓ Inspektionen sicher bestehen
✓ Workshop: Inspektionsverhalten
✓ Change Control
✓ Risikobewertung: Einfluss von Änderungen
✓ GMP-Dokumentation
✓ Änderungen EU-GMP Kapitel 4
Intensivseminar für Reinraum Quereinsteiger
Seminar-Themen
✓ Anforderungen der Behörden
✓ GMP, Dokumentation
✓ Personal- und Betriebshygiene
✓ Zonenkonzepte
✓ Risikoanalysen
✓ Reinigung und Desinfektion
✓ Reinraumbekleidung inkl. Workshop
✓ Outsourcing
✓ Monitoring in reinen Räumen
✓ Umgang mit Abweichungen
✓ Mit Workshop im Reinraum
31. Swiss Cleanroom Community Event
Dieses Event bietet der GMP – und Reinraumbranche das optimale Ambiente für einfaches und erfolgreiches Networking. Nutzen Sie diese face-to-face experience und generieren Sie hochwertige Leads!
56 Firmen präsentieren mit eigenem Stand und kompetenten Mitarbeitern ihre Produkte und Dienstleistungen. Die mehr als 370 Teilnehmer des Events kommen ihrerseits aus über 210 Firmen.
Das Event beginnt mit dem Hauptreferat, gefolgt von 8 informativen Kurzreferaten, die den Besuchern aktuelle Themen, neue Produkte und Dienstleistungen sowie innovative Neuheiten rund um GMP und Reinraum vorstellen.
Risikomanagement - ICH Q9
Seminar-Themen
✓ Quality Risk Management (QRM)
✓ Einsatz von Risikoanalysen
✓ Änderungen in der ICH Q9 von 2023
✓ Annex 1 und die Kontaminationskontrollstrategie
✓ Abweichungs- und Risikomanagement
✓ Workshop: Fallstudie Risikomanagement
✓ Risikomanagement an Praxisbeispielen
- Cross Kontamination in der Herstellung von sterilen Produkten
- Vorgehen der FvP bzw. QP bei der Produktefreigabe
Reinigungsvalidierung im GMP-Umfeld
Seminar-Themen
✓ Reinigungsverfahren
✓ Grundlagen der Reinigungsvalidierung
✓ Akzeptanzkriterien bei der Reinigungsvalidierung
✓ Probenahmeverfahren
✓ Praktische Umsetzung der Anforderungen in der Wirkstoffproduktion
✓ Workshop Planung einer Risikoanalyse / Milestones
✓ Analytik bei der Reinigungsvalidierung
✓ Reinigungsvalidierung aus Sicht der Behörde
GMP-Aufbauwissen
Seminar-Themen
✓ GMP-Zonenkonzepte
✓ Verhalten in reinen Räumen
✓ Anforderungen an die Reinraumbekleidung
✓ Workshop: Richtig angezogen in den Reinraum
✓ Reinigung in GMP-Zonen
✓ Anforderungen an die Betriebs- und Personalhygiene
✓ GMP gerechte Dokumentation
✓ Aufbau und Struktur von SOPs
✓ Abweichungen und Änderungen
✓ Qualifizierung von Mitarbeitern
Erfolgreiche Teamführung im Reinraum
Seminar-Themen
✓ Anforderungen an den Reinraummitarbeiter
✓ Auswahl von geeigneten Mitarbeitenden
✓ Bewerbergespräche zielorientiert führen
✓ Einführung von Mitarbeitenden in die Arbeit im Reinraum
✓ Was macht ein Team im Reinraum erfolgreich?
✓ Kommunikation gewinnbringend einsetzen
✓ Wie managt man reinraumtypische Konflikte?
✓ Workshop: Rollenspiele reinraumtypischer Konflikte
✓ Konstruktiver Umgang mit schwierigen Situationen
✓ Workshop: Ihre Fragestellungen aus der Praxis
Anforderungen an Smoke Studies
Seminar-Themen
✓ Annex 1 – CCS
: Kontaminationswege erkennen und sinnvoll umsetzen
✓ Risikoanalysen
Kritische Schritte identifizieren und Risiken steuern
✓ Smoke Study versus CFD (Computational Fluid Dynamics)
Methoden vergleichen, Nutzen erkennen
✓ Praktische Smoke-Study-Vorführung im Reinraum
Durchführung, Interpretation von Abweichungen
✓ Vom Drehbuch zum Validierungsbericht
✓ Umgebungsmonitoring
Mikrobiologische Qualifizierung und Umgang mit Abweichungen
Computervalidierung und Datenintegrität
Seminar-Themen
✓ Einführung in die Computervalidierung behördliche Vorgabedokumente
✓ Was versteht man unter Datenintegrität?
✓ Vorstellung des GAMP 5
✓ Was erwarten uns mit der Revision des Annex 11?
✓ Aspekte des neuen Risk approach
✓ Erläuterung der Annexe
✓ GAMP 5 in der Praxis Umsetzung am Beispiel eines Monitoring Systems
✓ Wichtige Punkte bei Projektabwicklung
✓ Was möchte ein Inspektor sehen
✓ Was sind immer wieder „Findings“?
✓ Was fordert der neue GAMP 5 Version 2.0?
GMP-Auditoren Training
Seminar-Themen
✓ Die Rolle des GMP-Auditors im Qualitätssystem
✓ Risikobasierte Auditplanung nach ICH Q9
✓ Lieferantenaudits in der pharmazeutischen Industrie
✓ Umgang mit Konflikten in Audits
✓ Workshop: Übungen anhand praktischer Beispiele/Feedback
✓ Souverän durch schwierige Auditsituationen
✓ Auditberichte und Nachverfolgung
Anforderungen an die QA-Oversight
Seminar-Themen
✓ Anforderungen an die QA-Oversight
✓ Aufgaben der QA-Oversight
✓ Kommunikation der Findings bzw. Abweichungen
✓ Feedback von Abweichungen
✓ Workshop: Wie kommunizieren Sie Abweichungen professionell
✓ Ausbildung der Linienmitarbeiter
✓ Inspektion der QA-Oversight
Reinheit und Messtechnik für pharmazeutische Gase
Seminar-Themen
✓ Qualitätsanforderungen an pharmazeutische Gase
✓ Betrieb, Wartung und Monitoring von Gasverteilsystemen
✓ Qualifizierung von Gasverteilsystemen
✓ Anforderungen an sterile Gase
✓ Einsatz von Risikoanalysen
✓ Qualitätsmessungen von pharmazeutischen Gasen
✓ Partikelmessung in pharmazeutischen Gasen
✓ Workshop: Partikel- & Keimmessung in pharmazeutischen Gasen
✓ Viable monitoring in compressed gas
✓ Bestimmung von pharmazeutischen Gasen
Anforderungen an Excel im GMP-Umfeld
Seminar-Themen
✓ Validierung von Software
✓ Datenintegrität
✓ GAMP 5 - Validierung von Excel Spreadsheets
✓ Appendix S3 – End User Applications Including Spreadsheets
✓ EDQM Annex 1 – Validation of Excel Spreadsheets
✓ Autit trail in MS Excel
✓ Firmenspezifische Umsetzung der GAMP 5 Vorgaben
✓ Risikobasierte Excel Spreadsheet Erstellung
✓ Umgang mit Makros und VBA
✓ Inspektion von Excel Spreadsheets
Konzepte zur Reinraum-Dekontamination
Seminar-Themen
✓ Kontaminationskontrollstrategie
✓ H2O2- Dekontamination von Räumen und deren Validierung
✓ Dekontamination von Räumen und deren Validierung
✓ Workshop: Identifizieren Sie Reinraum-Kontaminationsursachen
✓ Abweichungsmanagement in der Praxis
✓ H2O2- versus Formalin-Begasung
✓ Dekontaminationen im Labor der Biosicherheitsstufe 3
Train the Trainer im GMP-Umfeld
Seminar-Themen
✓ Anforderungen an das Schulungsmanagementsystem
✓ GMP-Trainings heute
✓ Behördliche Anforderungen an die Schulung
✓ Was erwartet der Inspektor von GMP-Schulungen
✓ Train the Trainer
✓ Umgang mit schwierigen Situationen
✓ Workshop Kommunikation, Präsentationstechnik
✓ Abwechslungsreicher Methodeneinsatz
✓ Aufbau und Gestaltung von Schulungen
Effizientes Projektmanagement
Seminar-Themen
✓ Projektidee- und Umsetzung
✓ Baubewilligung, Kontakt mit den Behörden
✓ Effiziente Projektorganisation
✓ Die richtigen Schutzkonzepte wählen
✓ Was zeichnet einen guten Projektstart aus?
✓ Anforderungen an den Reinraumbau
✓ Behördliche Anforderungen an Reinraumprojekte
Reinraumanforderungen in der Medizintechnik
Seminar-Themen
✓ GMP-Grundlagen für die Medizintechnik
✓ Schutzkonzepte für reine Räume
✓ Betriebs- und Personalhygiene
✓ Workshop: Händedesinfektion
✓ Mikrobiologie und kontaminationen
✓ Anforderungen an die Reinraumbekleidung
✓ Workshop: Ankleidequalifizierung
✓ Reinigung, Desinfektion und Sterilisation
Schutzkonzepte für Mitarbeiter in der Pharma-Industrie
Seminar-Themen
✓ Schutzkonzepte in reinen Räumen
✓ Schutzkonzepte für Mitarbeiter
✓ Arten, Auswahl und Einsatz von PSA
✓ Reinraumtaugliche Gebläse-Systeme
✓ Normen und Vorgaben zu PSAs und Kontaminationen
✓ Workshop
An- und Abziehen von PSA inklusive Dekontamination
Anforderungen an die Dampfsterilisation
Seminar-Themen
✓ Behördliche Anforderungen an die Dampfsterilisation
✓ Inspektion der Dampfsterilisation
✓ Change Control / Umgang mit Abweichungen
✓ Workshop Beladung und Verfahren auf was ist zu achten?
✓ Technische Anforderungen an Dampfsterilisatoren
✓ Qualifizierung aus der Sicht des Betreibers
✓ Qualifizierung aus der Sicht eines Dienstleisters
✓ Wartung eines Dampfsterilisators
✓ Revalidierung der Sterilisationsprogramme
Reinraum Praxisseminar
Seminar-Themen
✓ Schutzkonzepte für reine Räume
✓ Verhalten in reinen Räumen
✓ Workshop:
Schutzkonzepte
Verhaltensweisen in reinen Räumen
✓ Anforderungen an die Reinraumbekleidung
✓ Workshop im Reinraum
Wie kann ich Fehler beim Anziehprozedere vermeiden
✓ Reinigungs- und Desinfektionstechniken für Reinräume
Reinraumbau, Technik, Betrieb und Unterhalt
Seminar-Themen
✓ Anforderungen an reine Räume
✓ Zonenkonzepte - Annex 1
✓ Anforderungen an den Reinraumbau, Schleusen
✓ Projektplanung von Hygienezonen
✓ Anforderungen an die Luftfilter
✓ Anforderungen an ein Monitoring-System
✓ Umgebungsmonitoring / Umgang mit Abweichungen
✓ Unterhalt und technische Dokumentation von reinen Räumen
✓ Reinraumüberwachung gem. ISO 14644-2
Anforderungen an die FvP im GMP-Umfeld
Seminar-Themen
✓ Anforderungen an die FvP im Heilmittelgesetz
✓ Der Product Quality Review (PQR)
✓ Unterschiede zwischen PQR und APR (USA)
✓ Effektive CAPA (Corrective and Preventive Action)
✓ Deviation / Investigation
✓ Workshop: Verhalten und Aufgaben bei Inspektionen
✓ Erwartungen des Inspektors an die FvP bei Inspektionen
✓ Gesprächs- und Deeskalationstechniken
✓ Tipps und Tricks im Konfliktmanagement
Intensivseminar für Reinraum Quereinsteiger
Seminar-Themen
✓ Anforderungen der Behörden
✓ GMP, Dokumentation
✓ Personal- und Betriebshygiene
✓ Zonenkonzepte
✓ Risikoanalysen
✓ Reinigung und Desinfektion
✓ Reinraumbekleidung inkl. Workshop
✓ Outsourcing
✓ Monitoring in reinen Räumen
✓ Umgang mit Abweichungen
✓ Mit Workshop im Reinraum
GMP in der Kosmetik-Industrie
Seminar-Themen
✓ GMP-Grundlagen für die Kosmetik-Industrie
✓ Hygiene- und Schutzkonzepte im kosmetischen Bereich
✓ Betriebs- und Personalhygiene
✓ GMP-Dokumentation
✓ Mikrobiologie und Kontaminationen
✓ Reinigung und Desinfektion
Reinstwasser im GMP-Umfeld
Seminar-Themen
✓ Herstellverfahren und regulatorische Anforderungen an Pharmawasser
✓ GMP-gerechtes Design & Engineering von Wasseranlagen
✓ Erzeugung verschiedener Wasserqualitäten inkl. WFI-Membrantechnologie
✓ Werksbesichtigung mit Praxisgruppen (Probenahme, Messinstrumente, Anlagenbewertung)
✓ Qualifizierung von Anlagen und Steuerungssystemen (ALCOA+, Datenintegrität)
✓ Online-Messung mikrobiologischer Parameter
✓ Monitoring-Programme, PQ-Phase und Routinebetrieb
✓ Biofilmrisiken, Deviation- und CAPA-Management
✓ Typische „Findings“ – worauf Inspektoren achten.
Reinraum-Lufttechnik sicher qualifizieren
Seminar-Themen
✓ Anforderungen an die Reinraum-Lufttechnik
✓ Schutzkonzepte für reine Räume
✓ Einsatz von Risikoanalysen
✓ Anforderungen an die Luftfilter
✓ Werksbesichtigung
✓ Sicherheitsgehäuse für BSL3 und BSL4
✓ Reinraum-Qualifizierung und Reinraum-Überwachung
✓ Anforderungen an die Qualifizierung
Mikrobiologie im GMP-Umfeld
Seminar-Themen
✓ Einführung in die Mikrobiologie
✓ Reinraumorientierte Mikrobiologie
✓ Mikrobiologisches Monitoring
✓ Reinigung, Desinfektion und Sterilisation
✓ Validierung von Desinfektionsmitteln
✓ Workshop
- Monitoring – Geräte und Nährmedien, Durchführung und Auswertung
- Reinigung und Desinfektion
✓ GMP-gerechte Dokumentation / Hygienekonzepte
✓ Outsourcing von mikrobiologischen Arbeiten
Reinraum-Basiswissen
Seminar-Themen
✓ GMP-Grundwissen, Geschichte
✓ Reinraumverhalten, Einschleusen
✓ GMP-Zonen und Schleusen
✓ Betriebs- und Personalhygiene
✓ Reinigung, Desinfektion und Sterilisation
✓ Praktische Übungen
✓ Mikrobiologie und kontaminationen
✓ Anforderungen an die Reinraumbekleidung
31. Swiss Cleanroom Community Event
Dieses Event bietet der GMP – und Reinraumbranche das optimale Ambiente für einfaches und erfolgreiches Networking. Nutzen Sie diese face-to-face experience und generieren Sie hochwertige Leads!
56 Firmen präsentieren mit eigenem Stand und kompetenten Mitarbeitern ihre Produkte und Dienstleistungen. Die mehr als 300 Teilnehmer des Events kommen ihrerseits aus über 150 Firmen.
Das Event beginnt mit dem Hauptreferat, gefolgt von 8 informativen Kurzreferaten, die den Besuchern aktuelle Themen, neue Produkte und Dienstleistungen sowie innovative Neuheiten rund um GMP und Reinraum vorstellen.
Reinraum Qualifizierung und Monitoring
Seminar-Themen
✓ Die Qualifizierung des Reinraumes
✓ Messtechnik gemäss ISO 14644-1
✓ Anforderungen der ISO 14644-2
✓ Prüfverfahren für physikalische Parameter gemäss ISO 14644-3
✓ Aspekte der Reinraummessgeräte
✓ Praktischerteil im Reinraum
✓ Anforderungen des Annex 1
✓ Praktische Durchführung von Kalibrationen im Prüflabor
Datenintegrität im Fokus
Seminar-Themen
✓ Data Lifecycle und das ALCOA+-Konzept
✓ Anforderungen an Data Governance und risikobasierte Umsetzung
✓ Behördenvorgaben und Inspektionsschwerpunkte (EU/FDA)
✓ Findings von Datenintegritätsverletzungen aus FDA-Warning Letters
✓ Datenintegrität bei ausgelagerten Tätigkeiten
✓ Revisionen von EU-GMP Chapter 4 und Annex 11 sowie der neue Annex 22
✓ Umgang mit Datenintegritätsbefunden
✓ Beispiel einer möglichen firmeninternen Umsetzung (SOP)
Modul: Hygiene und Reinigung
Themen
Betriebs- und Personalhygiene
✓ Hygiene-Anforderungen
✓ Anforderungen an das Personal
✓ Anforderungen an Räume und Equipment
Reinigung und Desinfektion
✓ Reinigung- und Desinfektionsmittel
✓ Korrekte Aufbereitung von GMP-Zonen
✓ Typische Schwierigkeiten in der Praxis
Modul: Hygiene und Bekleidung
Themen
Betriebs- und Personalhygiene
✓ Hygiene-Anforderungen
✓ Anforderungen an das Personal
✓ Anforderungen an Räume und Equipment
Bekleidung und Verhalten
✓ Bekleidungskonzepte
✓ Einschleusen in GMP-Zonen
✓ Umgang mit Abweichungen
Modul: QM-System und Qualifizierung
Themen
QM-System
✓ Was verstehen wir unter Qualität?
✓ ISO 9000 - neu mit dem risikobasierten Ansatz
✓ QM-System und QM-Handbuch Umsetzung
Qualifizierung
✓ Aufbau und Ziel einer Qualifizierung
✓ Phasen einer Qualifizierung
✓ Risikoanalyse
✓ Dokumentation
Modul: Zonenkonzepte und Bekleidung
Themen
Zonenkonzepte
✓ Anforderungen an GMP-Zonen
✓ Aufbau von GMP-Zonen
✓ Auswirkungen auf die Produktion
Bekleidung und Verhalten
✓ Bekleidungskonzepte
✓ Einschleusen in GMP-Zonen
✓ Umgang mit Abweichungen
Modul: Dokumentation und Verhalten
Themen
GMP gerechte Dokumentation
✓ Aufbau des Dokumentensystems
✓ Erwartungen der Behörden
✓ Fehlerhafte GMP-Dokumente
Verhalten im Reinraum
✓ Bekleidungskonzepte
✓ Einschleusen in GMP-Zonen
✓ Umgang mit Abweichungen
Modul: GMP und Bekleidung
Themen
GMP- Entwicklung und Trends
✓ Hintergründe der GMP-Richtlinien
✓ Zielsetzung der GMP
✓ Trends
Bekleidung und Verhalten
✓ Bekleidungskonzepte
✓ Einschleusen in GMP-Zonen
✓ Umgang mit Abweichungen
Modul: Hygiene und Reinigung
Themen
Betriebs- und Personalhygiene
✓ Hygiene-Anforderungen
✓ Anforderungen an das Personal
✓ Anforderungen an Räume und Equipment
Reinigung und Desinfektion
✓ Reinigung- und Desinfektionsmittel
✓ Korrekte Aufbereitung von GMP-Zonen
✓ Typische Schwierigkeiten in der Praxis
Modul: Mikrobiologie und Monitoring
Themen
Mikrobiologie und Kontaminationsrisiken
✓ Wie schädigen Mikroorganismen?
✓ Das 5M Prinzip der Kontamination
✓ Einsatz von Risikoanalysen
Das mikrobiologische Monitoring
✓ Reinraum-Qualifizierung
✓ Probennahme, Inkubation, Auswertung
✓ Massnahmen bei Abweichungen
Modul: GMP und Behörden
Themen
GMP - Entwicklung und Trends
✓ Hintergründe der GMP-Richtlinien
✓ Zielsetzung der GMP
✓ Trends
Struktur der Behörden, Aufbau
✓ WHO, FDA, EMA, Swissmedic, RHI
✓ Was erwarten die Inspektoren
✓ Aufbau der Behörden und Verbände
Modul: Reinraumbau und Lufttechnik
Themen
Reinraumbau
✓ Grundlagen und Regelwerke
✓ Reinraumdecken- und Reinraumwandsysteme
✓ Anforderungen an die Reinraumböden
Lufttechnik
✓ Filtereinteilung
✓ Funktionsweise von Filtermedien
✓ Filtereinsatz für reine Räume
Modul: Der neue Annex 1
Themen
Der neue Annex 1
✓ Pharmazeutisches Qualitätssystem (PQS)
✓ Qualitätsrisikomanagement (QRM)
✓ Kontaminationskontrollstrategie (CCS)
✓ Was ist neu am Annex 1?
✓ Wie ist der Annex 1 aufgebaut?
✓ Was müssen Sie jetzt beachten?